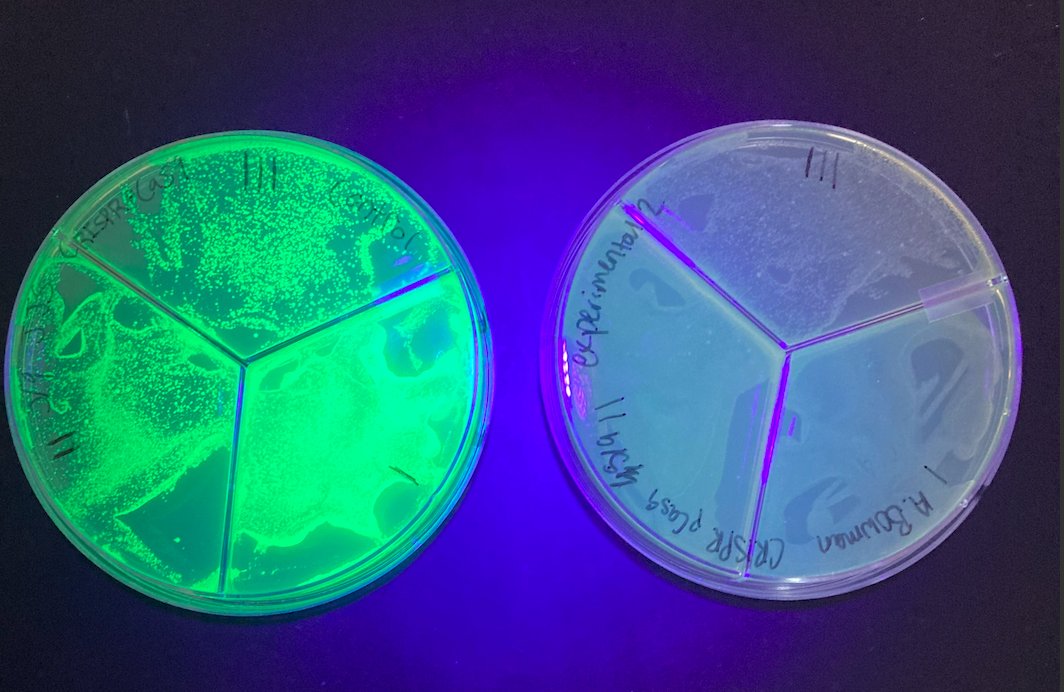
Student designed and executed CRISPR knockout of GFP. Control (left) and experimental (right). Pretty neat reading about this for the first time just a handful of years ago and now my students are performing it in a high school lab.

Kyle Erlenbeck
@erlenbeck
A frequently disappointed optimist whose ambition is to be a decent human being in an indecent world.
ID: 2369336306
https://elasticcollisions.wordpress.com/ 02-03-2014 20:10:18
1,1K Tweet
197 Takipçi
228 Takip Edilen

A great celebration for our CV Biotech program! A student-written Opportunity Grant from the Foundation for Douglas County Schools. A huge thanks to the Foundation. Such a tremendous benefit for this fantastic program. Castle View Events Douglas County School District Kyle Erlenbeck















#Denver will be one of the most expensive cities to live in by the end of 2022. Not surprising, 17% of our housing inventory has been purchased by investors who care about profits over people This is unsustainable, and why we support No Eviction Without Representation Denver Rep. Javier Mabrey and Elisabeth